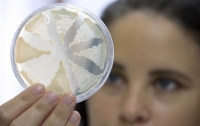
В Украине ухудшилась санэпидемситуация

ВСЕ НОВОСТИ
-
 20:18 Происшествия
20:18 Происшествия
На Донбассе подросток отравилась неизвестным веществом
-
 17:00 Происшествия
17:00 Происшествия
Вспышка инфекции в санатории Очакова: массово отравились дети
-
 17:00 Мир
17:00 Мир
В США произошло массовое отравление фруктами из Мексики
-
 22:38 Происшествия
22:38 Происшествия
Отравление детей в санатории Бердянска: количество отравившихся увеличилось
-
 06:35 Харьков
06:35 Харьков
Под Харьковом в детских лагерях нашли кишечную палочку
-
17:32 Здоровье
Кишечная инфекция в Черновицкой области: пострадало 28 человек
-
 05:31 Киев
05:31 Киев
В Киеве зафиксирован еще один случай ботулизма
-
 05:31 Киев
05:31 Киев
Массовое отравление суши в столице: у повара ресторана обнаружена сальмонелла
-
22:49 Общество
22:49 Общество
В Украине ухудшилась санэпидемситуация
-
 06:29 Киев
06:29 Киев
Из-за отравлений и ботулизма в Киеве усилили контроль за качеством продуктов
-
 18:49 Киев
18:49 Киев
Скандал в суши-баре Киева: в Госпотребслужбе назвали точное количество отравившихся
-
 23:05 Киев
23:05 Киев
Скандал с отравлением суши в Киеве: еще одна жертва подтвердила ЧП
-
 21:15 Киев
21:15 Киев
Опасные суши: киевляне отравились морскими деликатесами
-
 07:52 Харьков
07:52 Харьков
Массовое отравление детей в Харькове: врачи бьют тревогу




